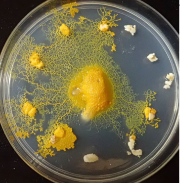
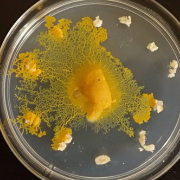
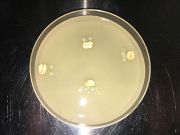
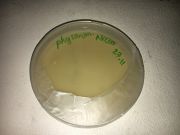
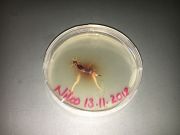
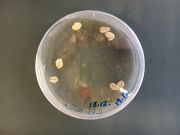
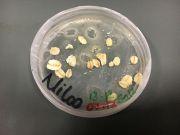

This special page shows all uploaded files.
| Date | Name | Thumbnail | Size | Description | Versions |
|---|---|---|---|---|---|
| 01:12, 2 January 2019 | Bio1 (49).PNG (file) |  |
938 KB | File uploaded with MsUpload | 1 |
| 01:12, 2 January 2019 | Bio 1(48).PNG (file) | |
961 KB | File uploaded with MsUpload | 1 |
| 01:12, 2 January 2019 | Bio (47).PNG (file) | |
926 KB | File uploaded with MsUpload | 1 |
| 01:12, 2 January 2019 | Bio (46).PNG (file) |  |
822 KB | File uploaded with MsUpload | 1 |
| 01:12, 2 January 2019 | Bio 1(44).PNG (file) |  |
626 KB | File uploaded with MsUpload | 1 |
| 01:12, 2 January 2019 | Bio (42).PNG (file) |  |
726 KB | File uploaded with MsUpload | 1 |
| 01:12, 2 January 2019 | Bio 1(41).PNG (file) |  |
599 KB | File uploaded with MsUpload | 1 |
| 01:07, 2 January 2019 | Main concept3.PNG (file) |  |
267 KB | File uploaded with MsUpload | 1 |
| 01:07, 2 January 2019 | Main concept2.PNG (file) |  |
249 KB | File uploaded with MsUpload | 1 |
| 01:06, 2 January 2019 | Main concept1.jpg.PNG (file) |  |
267 KB | File uploaded with MsUpload | 2 |
| 01:06, 2 January 2019 | Main concept.jpg.PNG (file) |  |
249 KB | File uploaded with MsUpload | 2 |
| 01:04, 2 January 2019 | Concept2222.png (file) |  |
267 KB | File uploaded with MsUpload | 1 |
| 01:04, 2 January 2019 | Concept1111.png (file) |  |
249 KB | File uploaded with MsUpload | 1 |
| 00:53, 2 January 2019 | Mian Concept2.png (file) |  |
267 KB | File uploaded with MsUpload | 1 |
| 00:53, 2 January 2019 | Mian Concept1.png (file) |  |
249 KB | File uploaded with MsUpload | 1 |
| 23:12, 1 January 2019 | Bio (79).JPG (file) |  |
2.83 MB | File uploaded with MsUpload | 2 |
| 20:07, 1 January 2019 | Bio (64).JPG (file) | |
2.04 MB | File uploaded with MsUpload | 2 |
| 20:07, 1 January 2019 | Bio (62).JPG (file) | |
1.93 MB | File uploaded with MsUpload | 2 |
| 20:00, 1 January 2019 | Bio (58).JPG (file) |  |
1.86 MB | File uploaded with MsUpload | 2 |
| 20:00, 1 January 2019 | Bio (57).JPG (file) |  |
2.67 MB | File uploaded with MsUpload | 2 |
| 20:00, 1 January 2019 | Bio (53).JPG (file) |  |
2.28 MB | File uploaded with MsUpload | 2 |
| 20:00, 1 January 2019 | Bio (51).JPG (file) |  |
2.45 MB | File uploaded with MsUpload | 2 |
| 19:58, 1 January 2019 | Bio (40).JPG (file) |  |
2.52 MB | File uploaded with MsUpload | 2 |
| 19:58, 1 January 2019 | Bio (37).JPG (file) |  |
3.36 MB | File uploaded with MsUpload | 3 |
| 15:39, 1 January 2019 | Bio (255).PNG (file) |  |
672 KB | File uploaded with MsUpload | 1 |
| 15:25, 1 January 2019 | Bio (10).JPG (file) |  |
5.22 MB | File uploaded with MsUpload | 3 |
| 15:25, 1 January 2019 | Bio (6).JPG (file) |  |
2.45 MB | File uploaded with MsUpload | 3 |
| 15:11, 1 January 2019 | Bio (12).jpg (file) |  |
86 KB | File uploaded with MsUpload | 1 |
| 15:11, 1 January 2019 | Bio.jpg (file) |  |
99 KB | File uploaded with MsUpload | 1 |
| 15:08, 1 January 2019 | Bio 1.jpg (file) |  |
86 KB | File uploaded with MsUpload | 1 |
| 15:08, 1 January 2019 | Bio2.jpg (file) |  |
99 KB | File uploaded with MsUpload | 1 |
| 15:03, 1 January 2019 | Bio (41).JPG (file) | |
1.89 MB | File uploaded with MsUpload | 1 |
| 15:03, 1 January 2019 | Bio (48).JPG (file) |  |
1.64 MB | File uploaded with MsUpload | 1 |
| 14:06, 1 January 2019 | Bio (166).JPG (file) |  |
2.45 MB | File uploaded with MsUpload | 1 |
| 14:06, 1 January 2019 | Bio (165).JPG (file) | |
1.94 MB | File uploaded with MsUpload | 1 |
| 14:05, 1 January 2019 | Bio (157).JPG (file) |  |
2.31 MB | File uploaded with MsUpload | 1 |
| 14:05, 1 January 2019 | Bio (155).JPG (file) |  |
2.21 MB | File uploaded with MsUpload | 1 |
| 14:05, 1 January 2019 | Bio (147).JPG (file) |  |
2.26 MB | File uploaded with MsUpload | 1 |
| 14:05, 1 January 2019 | Bio (145).JPG (file) |  |
1.74 MB | File uploaded with MsUpload | 1 |
| 14:05, 1 January 2019 | Bio (144).JPG (file) |  |
1.73 MB | File uploaded with MsUpload | 1 |
| 14:05, 1 January 2019 | Bio (142).JPG (file) |  |
2.11 MB | File uploaded with MsUpload | 1 |
| 14:05, 1 January 2019 | Bio (139).JPG (file) |  |
2.32 MB | File uploaded with MsUpload | 1 |
| 13:50, 1 January 2019 | Bio (137).JPG (file) |  |
1.94 MB | File uploaded with MsUpload | 1 |
| 13:50, 1 January 2019 | Bio (135).JPG (file) |  |
2.05 MB | File uploaded with MsUpload | 1 |
| 13:50, 1 January 2019 | Bio (130).JPG (file) |  |
1.7 MB | File uploaded with MsUpload | 1 |
| 13:50, 1 January 2019 | Bio (127).JPG (file) |  |
1.83 MB | File uploaded with MsUpload | 1 |
| 13:50, 1 January 2019 | Bio (126).JPG (file) |  |
1.68 MB | File uploaded with MsUpload | 1 |
| 13:50, 1 January 2019 | Bio (124).JPG (file) |  |
1.59 MB | File uploaded with MsUpload | 1 |
| 13:50, 1 January 2019 | Bio (122).JPG (file) | |
1.87 MB | File uploaded with MsUpload | 1 |
| 13:50, 1 January 2019 | Bio (121).JPG (file) |  |
1.87 MB | File uploaded with MsUpload | 1 |